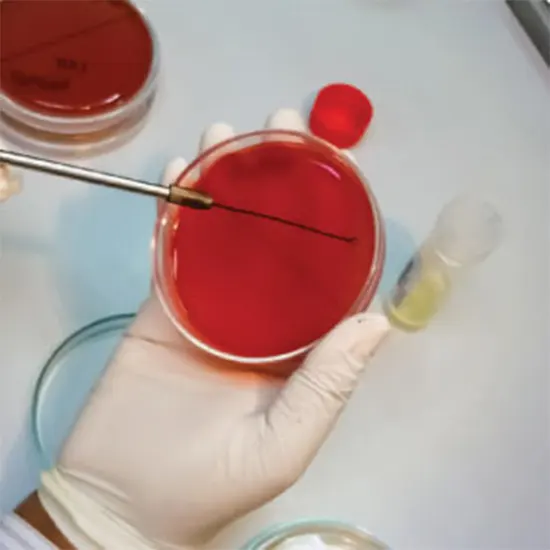

Book Ascitic Fluid Culture & Sensitivity Appointment Online Near me at the best price in Delhi/NCR from Ganesh Diagnostic. NABL & NABH Accredited Diagnostic centre and Pathology lab in Delhi offering a wide range of Radiology & Pathology tests. Get Free Ambulance & Free Home Sample collection. 24X7 Hour Open. Call Now at 011-47-444-444 to Book your Ascitic Fluid Culture & Sensitivity at 50% Discount.
Ascites are fluid buildup in the peritoneal space, the term for the abdominal cavity. This substance is known as ascitic fluid. The Culture and Sensitivity Ascitic Fluid test determines what is causing this fluid to form. Transudate and exudate are the two leading causes of this fluid buildup. Differentiating between these causes is much easier,r thanks to our analysis. Often, ascitic fluid is translucent or yellow. The data are analysed this way because the colour variation indicates the presence of medical issues. This test can detect severe disorders like pancreatitis, TB, and others.
The ascitic fluid should be collected when the abdomen is empty. To prepare the bladder for the test, you must urinate before it. You should dress appropriately for the process, as described below. When it comes to the medications you use regularly, consult your doctor. Certain medicines have an impact on the outcomes and should be avoided.
| Test Type | Ascitic Fluid Culture & Sensitivity |
| Includes | Ascitic Fluid Culture & Sensitivity (Pathology Test) |
| Preparation | |
| Reporting | Within 24 hours* |
| Test Price |
₹ 700
|

Early check ups are always better than delayed ones. Safety, precaution & care is depicted from the several health checkups. Here, we present simple & comprehensive health packages for any kind of testing to ensure the early prescribed treatment to safeguard your health.